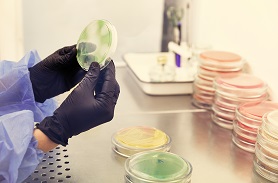

洗衣機(jī)除螨性能檢測(cè)方法及意義
 5次
5次
 2025.10.13
2025.10.13
在螨蟲(chóng)引發(fā)的皮膚過(guò)敏、呼吸道不適等健康問(wèn)題日益凸顯的當(dāng)下,洗衣機(jī)除螨功能成為眾多家庭選購(gòu)家電時(shí)的重要考量。然而,市場(chǎng)上部分產(chǎn)品僅靠宣傳話術(shù)標(biāo)榜“高效除螨”,實(shí)際效果卻參差不齊。此時(shí),洗衣機(jī)除螨性能檢測(cè)就成為關(guān)鍵——它不僅能科學(xué)驗(yàn)證產(chǎn)品性能,更能為消費(fèi)者健康、行業(yè)規(guī)范發(fā)展保駕護(hù)航。
洗衣機(jī)除螨性能檢測(cè)方法
1.高溫除螨檢測(cè)法
高溫是殺滅螨蟲(chóng)的經(jīng)典手段(屋塵螨在55℃以上持續(xù)10分鐘即可失活),這類檢測(cè)的核心是驗(yàn)證“實(shí)際水溫是否達(dá)標(biāo)、持續(xù)時(shí)間是否足夠”:
關(guān)鍵操作步驟:
負(fù)載設(shè)置:按GB/T30244-2013標(biāo)準(zhǔn),放入5kg標(biāo)準(zhǔn)負(fù)載(2.5kg試驗(yàn)棉織物+2.5kg配重棉),織物表面提前接種(1500±200)只/㎡的屋塵螨活螨;
程序啟動(dòng):選擇洗衣機(jī)“高溫除螨程序”,用高精度水溫傳感器(精度±0.5℃)實(shí)時(shí)監(jiān)測(cè)滾筒內(nèi)水溫,每5分鐘記錄1次數(shù)據(jù);
效果驗(yàn)證:程序結(jié)束后,采用“五點(diǎn)取樣法”采集織物樣本,通過(guò)螨蟲(chóng)分離裝置(溫度梯度式)分離活螨,在40倍顯微鏡下計(jì)數(shù),計(jì)算除螨率(公式:[(對(duì)照組活螨數(shù)-試驗(yàn)組活螨數(shù))/對(duì)照組活螨數(shù)]×100%);
2.紫外線除螨檢測(cè)法
部分洗衣機(jī)搭載UV-C紫外線燈,通過(guò)破壞螨蟲(chóng)核酸實(shí)現(xiàn)殺滅,檢測(cè)需兼顧“輻射強(qiáng)度、覆蓋范圍、安全性”:
關(guān)鍵操作步驟:
強(qiáng)度檢測(cè):在滾筒內(nèi)均勻布置5個(gè)紫外線強(qiáng)度檢測(cè)點(diǎn)(前、后、左、右、中心),啟動(dòng)紫外線除螨程序,用紫外線強(qiáng)度計(jì)(量程0-100μW/cm2)檢測(cè)各點(diǎn)輻射強(qiáng)度,需均≥30μW/cm2;
覆蓋驗(yàn)證:在織物不同位置(邊緣、中心、褶皺處)接種螨蟲(chóng),程序結(jié)束后檢查各位置除螨率,確保無(wú)“除螨盲區(qū)”;
安全測(cè)試:用紫外線檢測(cè)卡在洗衣機(jī)機(jī)身縫隙、艙門周圍測(cè)試,確認(rèn)無(wú)紫外線泄漏(泄漏量≤0.1μW/cm2),避免傷害人體。
洗衣機(jī)除螨性能檢測(cè)意義
(1)保障消費(fèi)者健康權(quán)益
螨蟲(chóng)及其排泄物、尸體是常見(jiàn)過(guò)敏原,易誘發(fā)過(guò)敏性鼻炎、哮喘、皮膚瘙癢等問(wèn)題,尤其對(duì)老人、兒童等敏感人群影響顯著。檢測(cè)能客觀判定洗衣機(jī)是否真能有效去除衣物、家紡中的活螨(如達(dá)到GB/T21551.5-2024要求的≥90%活螨去除率),避免“除螨”淪為宣傳噱頭,幫助消費(fèi)者切實(shí)減少生活環(huán)境中的螨蟲(chóng)過(guò)敏原,降低健康風(fēng)險(xiǎn)。
(2)規(guī)范市場(chǎng)競(jìng)爭(zhēng)秩序
若缺乏統(tǒng)一檢測(cè)標(biāo)準(zhǔn),部分企業(yè)可能夸大除螨效果,導(dǎo)致市場(chǎng)產(chǎn)品質(zhì)量參差不齊,消費(fèi)者難以辨別。通過(guò)檢測(cè),可依據(jù)明確標(biāo)準(zhǔn)對(duì)產(chǎn)品性能進(jìn)行量化評(píng)估,倒逼企業(yè)規(guī)范宣傳、提升產(chǎn)品實(shí)際除螨能力,避免虛假營(yíng)銷,維護(hù)公平競(jìng)爭(zhēng)的市場(chǎng)環(huán)境。
(3)引導(dǎo)產(chǎn)品技術(shù)優(yōu)化
檢測(cè)過(guò)程中對(duì)除螨效果的量化評(píng)估,能為洗衣機(jī)企業(yè)提供技術(shù)改進(jìn)方向——例如優(yōu)化除螨程序參數(shù)、研發(fā)更高效的除螨技術(shù),推動(dòng)行業(yè)從“概念除螨”向“技術(shù)有效除螨”升級(jí),最終提升產(chǎn)品整體品質(zhì)。
我們的服務(wù)
OUR SERVICES
-
 適用產(chǎn)品質(zhì)量法的“產(chǎn)品”的范圍是什么?產(chǎn)品質(zhì)量法第二條第二款規(guī)定,本法所稱產(chǎn)品,是指經(jīng)過(guò)加工廠、制作,用于銷售的產(chǎn)品。這一規(guī)定,以對(duì)“產(chǎn)品”下定義的方式,規(guī)定了適用產(chǎn)品質(zhì)量法規(guī)定的產(chǎn)品的范圍。
適用產(chǎn)品質(zhì)量法的“產(chǎn)品”的范圍是什么?產(chǎn)品質(zhì)量法第二條第二款規(guī)定,本法所稱產(chǎn)品,是指經(jīng)過(guò)加工廠、制作,用于銷售的產(chǎn)品。這一規(guī)定,以對(duì)“產(chǎn)品”下定義的方式,規(guī)定了適用產(chǎn)品質(zhì)量法規(guī)定的產(chǎn)品的范圍。 -
 中科認(rèn)證教您如何選擇產(chǎn)品質(zhì)量鑒定機(jī)構(gòu)?中科認(rèn)證教您如何選擇產(chǎn)品質(zhì)量鑒定機(jī)構(gòu)?
中科認(rèn)證教您如何選擇產(chǎn)品質(zhì)量鑒定機(jī)構(gòu)?中科認(rèn)證教您如何選擇產(chǎn)品質(zhì)量鑒定機(jī)構(gòu)? -
 數(shù)控龍門銑鏜床油溫過(guò)高質(zhì)量分析針對(duì)數(shù)控龍門銑鏜床多次出現(xiàn)油溫過(guò)高故障報(bào)警導(dǎo)致停機(jī)問(wèn)題,中科認(rèn)證根據(jù)多起數(shù)控龍門銑鏜床質(zhì)量鑒定出現(xiàn)的案例,對(duì)該設(shè)備的過(guò)熱問(wèn)題進(jìn)行質(zhì)量技術(shù)分析。
數(shù)控龍門銑鏜床油溫過(guò)高質(zhì)量分析針對(duì)數(shù)控龍門銑鏜床多次出現(xiàn)油溫過(guò)高故障報(bào)警導(dǎo)致停機(jī)問(wèn)題,中科認(rèn)證根據(jù)多起數(shù)控龍門銑鏜床質(zhì)量鑒定出現(xiàn)的案例,對(duì)該設(shè)備的過(guò)熱問(wèn)題進(jìn)行質(zhì)量技術(shù)分析。 -
 洗衣機(jī)除過(guò)敏源性能試驗(yàn)方法及流程當(dāng)前不少洗衣機(jī)標(biāo)注 “除過(guò)敏源” 功能,但實(shí)際效果差異大 —— 部分產(chǎn)品可能僅靠常規(guī)洗滌程序,未針對(duì)過(guò)敏源特性設(shè)計(jì)專項(xiàng)技術(shù)。洗衣機(jī)除過(guò)敏源性能試驗(yàn)以統(tǒng)一、客觀的標(biāo)準(zhǔn),驗(yàn)證產(chǎn)品宣傳是否達(dá)標(biāo)。GB/T 21551.5-2024 《家用和類似用途電器的抗菌、除菌、凈化功能 第5部分:洗衣機(jī)的特殊要求》標(biāo)準(zhǔn)要求明示具有減少或去除特定過(guò)敏原功能的洗衣機(jī),對(duì)該過(guò)敏原的去除率不應(yīng)小于90.0%。
洗衣機(jī)除過(guò)敏源性能試驗(yàn)方法及流程當(dāng)前不少洗衣機(jī)標(biāo)注 “除過(guò)敏源” 功能,但實(shí)際效果差異大 —— 部分產(chǎn)品可能僅靠常規(guī)洗滌程序,未針對(duì)過(guò)敏源特性設(shè)計(jì)專項(xiàng)技術(shù)。洗衣機(jī)除過(guò)敏源性能試驗(yàn)以統(tǒng)一、客觀的標(biāo)準(zhǔn),驗(yàn)證產(chǎn)品宣傳是否達(dá)標(biāo)。GB/T 21551.5-2024 《家用和類似用途電器的抗菌、除菌、凈化功能 第5部分:洗衣機(jī)的特殊要求》標(biāo)準(zhǔn)要求明示具有減少或去除特定過(guò)敏原功能的洗衣機(jī),對(duì)該過(guò)敏原的去除率不應(yīng)小于90.0%。

















































